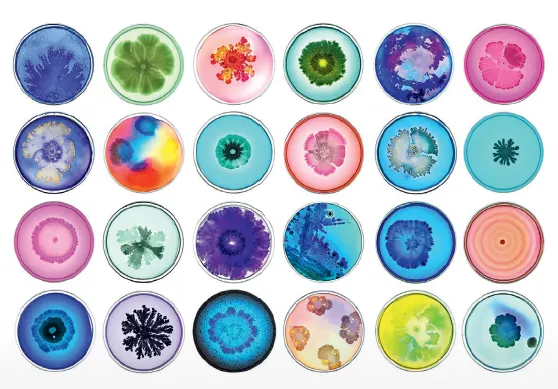

Le jeudi 14 novembre 2019 de 14h à 17h, le Service des maladies infectieuses des HUG vous invite à participer au prochain séminaire d'infectiologie pour les praticiens.
Programme
- 14h Immunosuppressions en ambulatoire : quelles prophylaxies et quand ?
Pr Christian Van Delden - 14h30 Présentation de cas interactifs
Equipe maladies infectieuses - 15h30 Pause café
- 16h Présentation de cas interactifs
Equipe maladies infectieuses - 16h30 Pied diabétique : le point de vue de l’infectiologue
Dr Truong-Thanh Pham
Quand?
- Jeudi 14 novembre 2019, de 14h à 17h
Où?
- Muséum d'Histoire Naturelle,
Route de Malagnou 1, 1208 Genève
Inscriptions
Inscription obligatoire au travers de ce formulaire
Plus d'infos
- Programme
- Contacter Mme Berivan Mutlu au 022 372 98 00 ou via mail berivan.mutlu@hug.ch